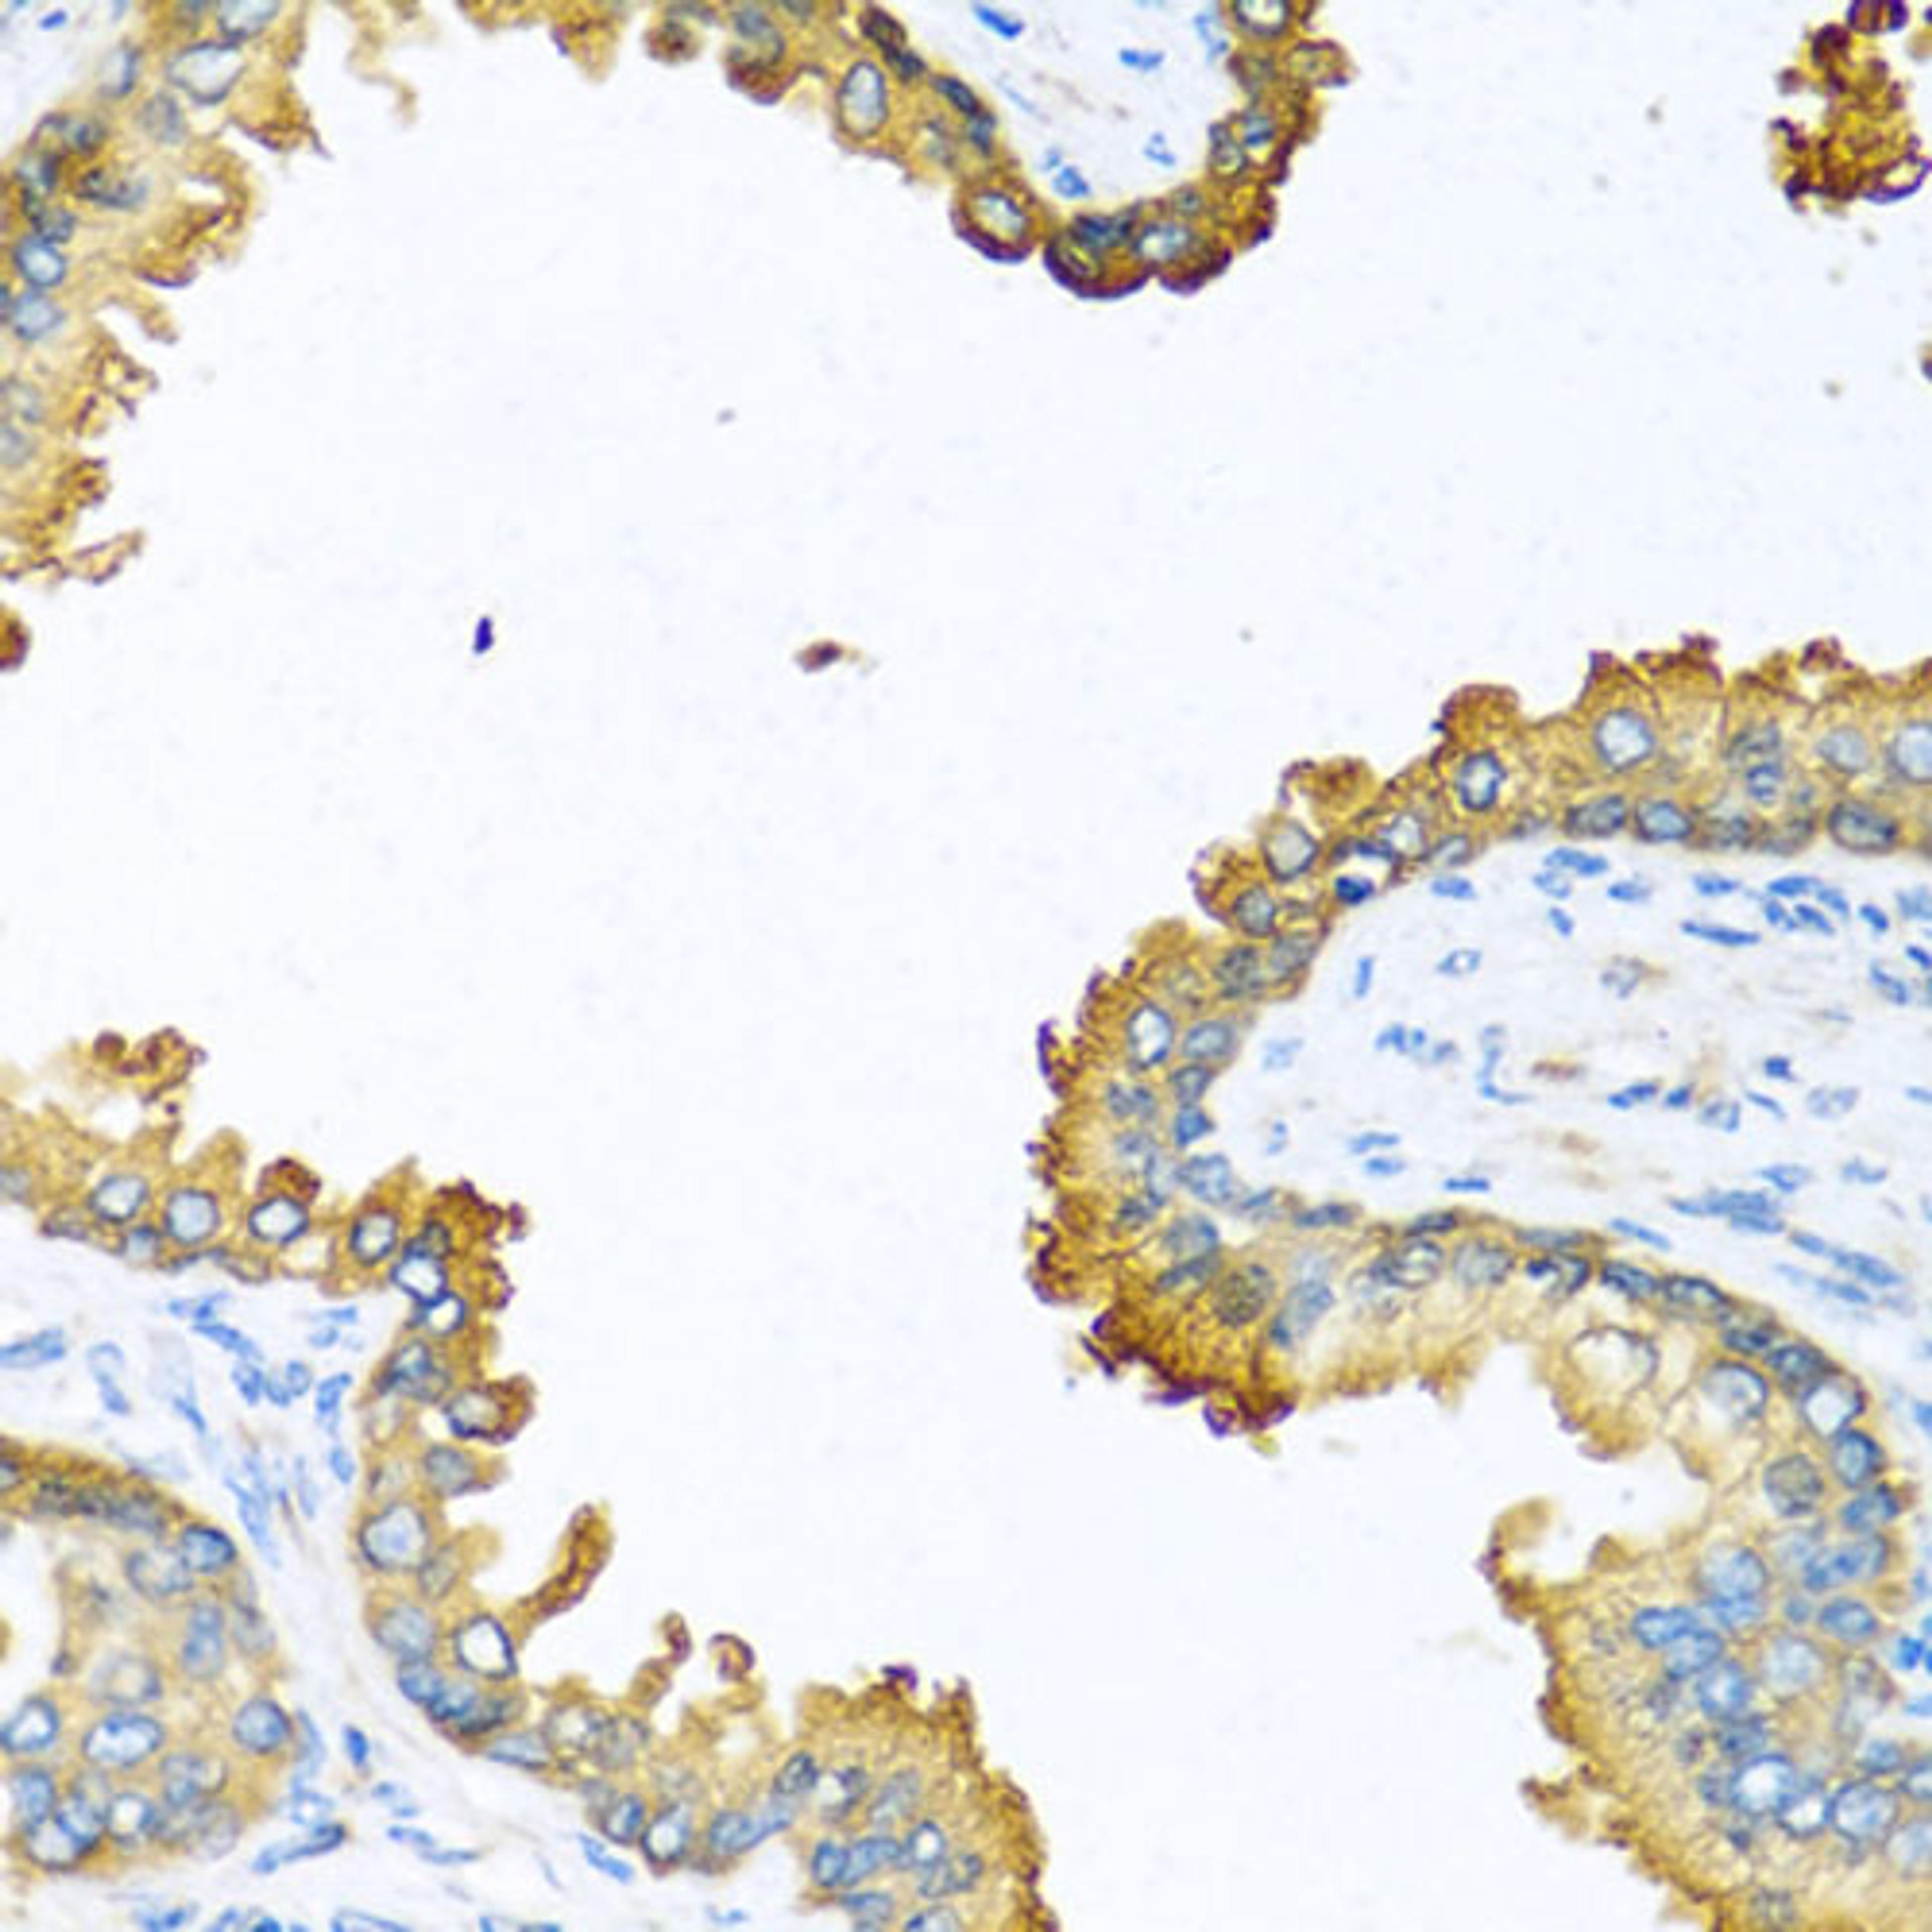
Immunohistochemistry - VEGFC antibody (A12530)

Product & ReviewsAntibodies
VEGFC Rabbit pAb
Product Details
- Cat. No.
- A12530
- Type
- Primary Antibody
- Clonality
- Polyclonal
- Host
- Rabbit

The supplier does not provide quotations for this antibody through SelectScience. You can search for similar antibodies in our Antibody Directory.
Description
The protein encoded by this gene is a member of the platelet-derived growth factor/vascular endothelial growth factor (PDGF/VEGF) family. The encoded protein promotes angiogenesis and endothelial cell growth, and can also affect the permeability of blood vessels. The proprotein is further cleaved into a fully processed form that can bind and activate VEGFR-2 and VEGFR-3 receptors.
Biological Information
- Clonality: Polyclonal
- Host: Rabbit
- Reactivity: Human, Mouse